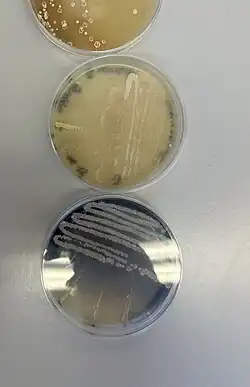

Agardiffusionstest
Agardiffusionstest ist ein Oberbegriff für immunologische und mikrobiologische Verfahren, bei denen sich die zu untersuchenden biologische Reagenzien in einem Agarmedium durch Diffusion ausbreiten.[1]
- Bei der Untersuchung von Antigenen mit Antikörpern wird der Immundiffusionstest angewendet (siehe auch Immunelektrophorese).
- Bei der Untersuchung von auf Mikroorganismen wachstumshemmend (Hemmstoffe wie Antibiotika) oder wachstumsfördernd (Vitamine, Aminosäuren) wirkenden Verbindungen findet der Plattendiffusionstest Anwendung. Eine Spezialanwendung des Plattendiffusionstests ist der Hemmhoftest.
Einzelnachweise
- ↑ Chandrakant Kokate: Textbook of Pharmaceutical Biotechnology. Elsevier India, 2011. ISBN 978-81-312-2828-9. S. 173.